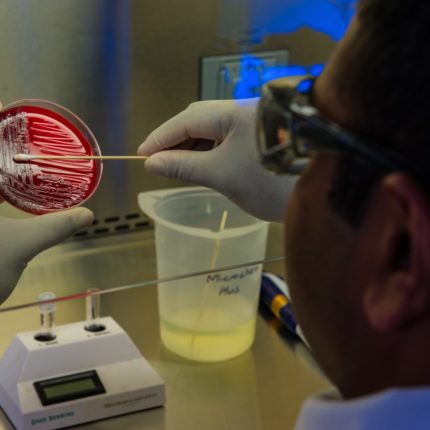

Blog Post In Divorce
All Posts
Living Together After Divorce: Do Couples Need to Physically Separate?
In Texas, couples do not need to physically separate after divorce, but continuing to live together can create legal complications. Shared housing may blur boundaries, increase conflict, or complicate enforcement of custody, support, and property…
Mutual Divorce: How to Separate Amicably in Richmond, TX
To separate amicably in Richmond, TX, couples typically pursue an uncontested mutual divorce by agreeing on all issues upfront. Both spouses must meet residency requirements, fully disclose finances, and agree on property division, debts, and…
How Long Does a Child Custody Case Take in Texas?
A child custody lawyer is a family law attorney who specializes in helping parents navigate conservatorship, possession, and access issues in Texas courts. The length of your custody case can vary significantly depending on whether…
What is No Fault Divorce in Texas?
If you’re having a hard time with your family in Richmond, Texas, you might be wondering if you can sign over custody of a child without going to court. Parents often ask this question when…
Can You Sign Over Custody of a Child Without Going to Court?
If you’re having a hard time with your family in Richmond, Texas, you might be wondering if you can sign over custody of a child without going to court. Parents often ask this question when…
Can I Take My Child Out Of State If There Is No Custody Order?
It’s a question that can weigh heavily on a parent’s heart, filled with hopes for a fresh start or worries about a necessary change: “Can I take my child out of state if there is…
How To Get Full Custody of a Child in Texas
Understanding how to get full custody of a child in Texas begins with recognizing the state’s preference for joint managing conservatorship in most cases. But when it can be shown that the child’s best interests…
Who Claims Child On Taxes With 50/50 Custody?
Many parents negotiating separation or divorce sometimes wonder, “who claims child on taxes with 50/50 custody?” This is a crucial question since the Child Tax Credit and other tax advantages can seriously affect your income….
If I Am Serviced Divorce Papers Do I Have To Sign Them?
Being served divorce papers can be a stressful and confusing experience, especially if you are unsure about your legal obligations. A common concern is, “If I am served divorce papers, do I have to sign…
What is an Ex Parte Order in Texas?
Navigating family law matters can be challenging, especially when urgent decisions are needed to protect your safety or legal rights. In such situations, ex-parte orders play a crucial role. An ex parte order is a…